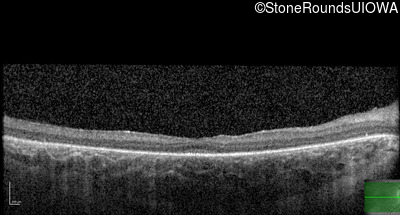
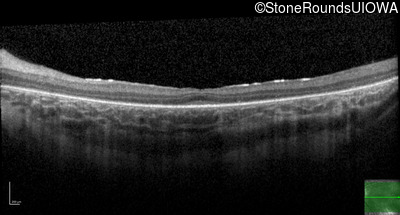
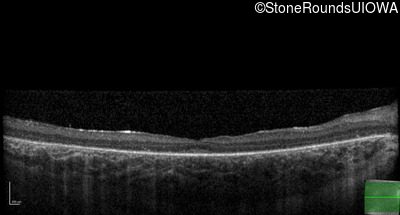
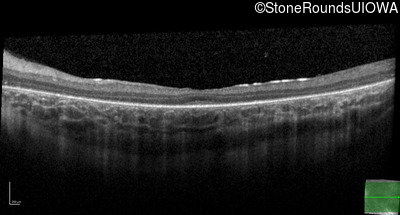
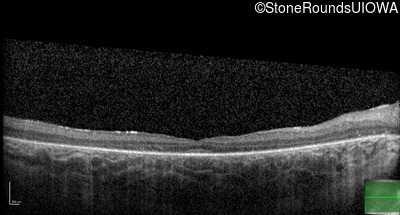
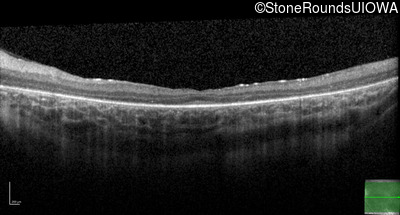
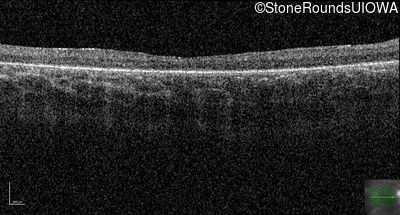

Case
SR1028
Student Mode
Usher Syndrome (IB1)
Female
Female
Hidden
SR1028
Student Mode
Usher Syndrome (IB1)
Female
Female
| Age at visit: 10 years |
| Age at visit: 11 years |
| Age at visit: 12 years |
| Age at visit: 13 years |
| Age at visit: 14 years |
| Age at visit: 16 years |
Diagnosis & molecular findings
| Disease | Gene | Allele 1 variant(s) | Allele 2 variant(s) | Inheritance mode |
|---|---|---|---|---|
| Usher Syndrome | TUBB4B | Glu410Lys GAG>AAG | AD |